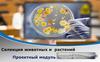
Селекция животных и растений

Similar presentations:
Профессия - кинолог
1.
ОАПОУ «Белгородский правоохранительный колледж имени Героя России В.В. Бурцева»Дашевская Вероника Сергеевна
студентка 2 курса
PPT模板下载 www.1ppt.com/moban/
节日PPT模板 www.1ppt.com/jieri/
PPT背景图片 www.1ppt.com/beijing/
优秀PPT下载 www.1ppt.com/xiazai/
Word教程 www.1ppt.com/word/
资料下载 www.1ppt.com/ziliao/
范文下载 www.1ppt.com/fanwen/
教案下载 www.1ppt.com/jiaoan/
字体下载 www.1ppt.com/ziti/
行业PPT模板 www.1ppt.com/hangye/
PPT素材下载 www.1ppt.com/sucai/
PPT图表下载 www.1ppt.com/tubiao/
PPT教程 www.1ppt.com/powerpoint/
Excel教程 www.1ppt.com/excel/
PPT课件下载 www.1ppt.com/kejian/
试卷下载 www.1ppt.com/shiti/
2.
Кинолог – интересная профессия с необычной, динамичной и отчасти творческой работы. Онатребует мощной теоретической подготовки и тонкого чувства психологии животного, умения
адаптировать программу обучения и дрессировки под индивидуальные особенности каждой
собаки. Специальность не самая «денежная», но большинство профессионалов с опытом не
бедствуют и располагают массой возможностей для подработок и фриланса.
Эта работа идеально подойдет смелым, интеллектуально развитым и безмерно любящим
животных людям. Она не будет легкой – на ваших плечах будет лежать колоссальная
ответственность. Но она точно придется вам по душе, если вы хотите связать свою жизнь с
собаками.
3.
Кинолог воспитывает и дрессирует собак,также
для
грамотного
разведения
специалист изучает их генеалогию, чтобы
создать пары для получения первоклассного
потомства с определёнными внешними
качествами или особенностями экстерьера. В
наше время кинология разделяется на
несколько различных специализаций, таких
как кинолог-инструктор, фигурант, он же
помощник инструктора, диетолог, фитнесинструктор и хэндлер.
4.
Как стать кинологомС каждым годом организаций, в которых учат на кинолога, становится все больше. Для максимальных
возможностей карьерного роста надо получить высшее образование. Самостоятельная работа в этом случае не
даст необходимых знаний, практических навыков и подтверждающих документов для старта деятельности. Еще
можно выучиться на ветеринара и прослушать дополнительные курсы.
колледж –
специальность
«Кинология» — 4 года
обучения после 9
классов и 3 года после
окончания школы;
ВУЗ – специальности
«Зоотехния»,
«Биотехнология» –
4-5 лет в
зависимости от
формы обучения;
Академия МВД,
МЧС,
ФТС – 6месячные курсы.
5.
Кинолог должен обладать личными качествами:Терпеливость
Любовь к собакам
Отсутствие аллергии на собачью
Организованность
шерсть
..
Смелость при работе с разными собаками
Доброжелательность
Выдержка
6.
Кинологу требуется высокая физическая работоспособность – ведь работа проходит преимущественно навоздухе, в любую погоду и связана с активными перемещениями. Кинологи – это специалисты по разведению и
воспитанию собак. Они изучают физиологию и особенности поведения четвероногих питомцев, учатся
использовать их умения для пользы человека. В основе всех этих знаний лежит наука о собаках – кинология.
Учение включает все тонкости собаководства, специфику взаимодействия людей и животных, правила ухода за
представителями отдельных пород. Чтобы освоить профессию необходимо не только отучиться в профильном
образовательном учреждении, но и выработать у себя ряд обязательных качеств.
Специфика работы кинологом.
На учебно-дрессировочных площадках кинологи готовят собак-спасателей, поводырей для слепых, служебнорозыскных собак. Натаскивают их на поиск взрывчатых и наркотических веществ. Кинологи инструктируют
владельцев собак, как дрессировать их домашних любимцев. Участвуют в национальных и международных
выставках, соревнованиях, конкурсах собак, сотрудничают с клубами любителей собак. Однако чаще кинолог – это
владелец собственной служебной собаки, подготовленной для выполнения определенных функций (поиск
взрывчатых и наркотических веществ, караульно-охранная служба, поиск и спасение пострадавших и т.д.)
PPT模板下载 www.1ppt.com/moban/
节日PPT模板 www.1ppt.com/jieri/
PPT背景图片 www.1ppt.com/beijing/
优秀PPT下载 www.1ppt.com/xiazai/
Word教程 www.1ppt.com/word/
资料下载 www.1ppt.com/ziliao/
范文下载 www.1ppt.com/fanwen/
教案下载 www.1ppt.com/jiaoan/
字体下载 www.1ppt.com/ziti/
行业PPT模板 www.1ppt.com/hangye/
PPT素材下载 www.1ppt.com/sucai/
PPT图表下载 www.1ppt.com/tubiao/
PPT教程 www.1ppt.com/powerpoint/
Excel教程 www.1ppt.com/excel/
PPT课件下载 www.1ppt.com/kejian/
试卷下载 www.1ppt.com/shiti/
7.
Понимание психологии и особенностей характера животного играет главную роль в его воспитании идрессировке.
При этом кинология имеет несколько направлений. В зависимости от выбранной специализации кинолог
может быть:
• Инструктором по физической подготовке.
• Дрессировщиком.
• Диетологом.
• Специалистом по воспитанию собак-защитников.
• Экспертом на специализированных соревнованиях, выставках.
• Зоопсихологом или «собачьим психологом».
• Хэндлером – специализироваться на комплексной подготовке собак к выставкам.
Но гораздо чаще все узкие профессии объединяются в одной – кинолог-специалист. Он следит за питанием
животного, занимается его дрессировкой, корректирует поведение, обучает и контролирует изменения
психики. Но нет никаких препятствий для ухода в «узкую» специализацию. А вот кинологу-диетологу стать
универсалом крайне сложно – придется проходить комплексную переподготовку и подтверждать
квалификацию.
8.
Для получения специальности недостаточно изучить базовую информацию о той или иной породе,универсальные принципы взаимодействия с животными. Кинолог – это многогранная профессия с рядом
специализаций. Ее представителю следует ориентироваться в анатомии и физиологии питомцев, специфике их
развития, нюансах становления характера в зависимости от назначения вида и условий содержания. Что
изучает и что делает специалист
Кинолог изучает собаководство во всех его проявлениях. Не стоит думать, что для дрессировки животного
достаточно знания определенного алгоритма. Не достаточно давать собаке еду за успешно выполненную
команду – необходимо знать особенности ее поведения в конкретной ситуации, чувствовать настроение,
следить за физическими показателями и проводить рациональные тренировки. Часто специалист не только
дрессирует и воспитывает животное, но и ухаживает за ним.
Что необходимо изучить:
01
03
05
Анатомию.
02
Алгоритмы дрессировки.
04
Основы ветеринарии.
Физиологию.
Психологию.
При этом кинолог – не ветеринар. Он не сможет провести
сложную операцию на позвоночнике или достать из желудка
животного случайно проглоченный гвоздь.
9.
Обязанности кинолога напрямую зависят от занимаемой им должности. Диетолог будет следить за питанием,психолог – корректировать поведение, специалист универсал – пытаться успевать все и сразу. Вполне возможно,
что в результате карьерного роста вам удастся занять более высокую должность и стать, например, начальником
кинологической службы. Не исключено, что вы откроете собственный дрессировочный центр или будете
предоставлять услуги как частный специалист. В любом случае, ключевая задача – это работа на благо здоровья и
профессиональной состоятельности собаки. Вне зависимости от должности.
Чем занимаются люди профессии кинолог
Большинство кинологов работают на таможне, в силовых структурах, в питомниках, в собаководческих центрах или
ведут частную практику – в каждой из этих отраслей вы контактируете с людьми. Важно уметь выстраивать
доверительные отношения с хозяевами переданных вам на воспитание собак. Важно быть умеренно лояльным с
гражданами, которых вы проверяете на таможне. Важно уметь оказывать психологическую помощь людям,
которых вы находите под завалами, работая в МЧС.
PPT模板下载 www.1ppt.com/moban/
节日PPT模板 www.1ppt.com/jieri/
PPT背景图片 www.1ppt.com/beijing/
优秀PPT下载 www.1ppt.com/xiazai/
Word教程 www.1ppt.com/word/
资料下载 www.1ppt.com/ziliao/
范文下载 www.1ppt.com/fanwen/
教案下载 www.1ppt.com/jiaoan/
字体下载 www.1ppt.com/ziti/
行业PPT模板 www.1ppt.com/hangye/
PPT素材下载 www.1ppt.com/sucai/
PPT图表下载 www.1ppt.com/tubiao/
PPT教程 www.1ppt.com/powerpoint/
Excel教程 www.1ppt.com/excel/
PPT课件下载 www.1ppt.com/kejian/
试卷下载 www.1ppt.com/shiti/
10.
Силовые структуры. Полиция, ФСБ, Вооруженные силы, ФСКН – кинологи требуются во всех отраслях охраныправопорядка и обеспечения безопасности. Служебные собаки помогают ловить преступников по горячим следам,
ищут взрывчатку и наркотические средства. Их роль при выполнении спецопераций сложно переоценить.
Специалисты получают звания и пользуются теми же льготами, что и другие сотрудники структур, служб,
подразделений.
Таможня. Обученные собаки помогают проверять грузовые и пассажирские железнодорожные составы, автомобили
и большие группы людей. Они ищут запрещенные к провозу через границу предметы и вещества,
Где могут работать кинологи
главным образом наркотические средства, медикаменты, алкогольную продукцию и взрывчатку. Кинологи также
проводят пограничные рейды, обследуют территорию, участвуют в операциях по поиску и задержанию людей,
незаконно пересекающих границу вне таможенных пунктов.
МЧС. Служебные собаки участвуют в поисковых операциях. Они находят людей в задымленных зданиях, улавливают
их запах и звуки под многотонными бетонными обломками при взрывах. Здесь от квалификации кинолога и
обученного им животного зависят десятки человеческих жизней – при чрезвычайных происшествиях счет всегда идет
на секунды. Чем быстрее собака обнаружит пострадавшего человека, тем большей будет вероятность его спасения.
PPT模板下载 www.1ppt.com/moban/
节日PPT模板 www.1ppt.com/jieri/
PPT背景图片 www.1ppt.com/beijing/
优秀PPT下载 www.1ppt.com/xiazai/
Word教程 www.1ppt.com/word/
资料下载 www.1ppt.com/ziliao/
范文下载 www.1ppt.com/fanwen/
教案下载 www.1ppt.com/jiaoan/
字体下载 www.1ppt.com/ziti/
行业PPT模板 www.1ppt.com/hangye/
PPT素材下载 www.1ppt.com/sucai/
PPT图表下载 www.1ppt.com/tubiao/
PPT教程 www.1ppt.com/powerpoint/
Excel教程 www.1ppt.com/excel/
PPT课件下载 www.1ppt.com/kejian/
试卷下载 www.1ppt.com/shiti/
11.
Массовость и уникальность профессии:В наше время растёт спрос на высококвалифицированных
специалистов-кинологов, потому что существуют
определённые отрасли, в которых работа хорошо обученной
собаки намного надёжней, чем человека. Собак
воспитывают для охраны частных владений, таможенного
контроля, также они незаменимы для работы в сложных
условиях, во время поиска выживших после катастроф.
Риски профессии:
Для успешной работы кинологом необходимо обладать
большим зарядом энергии, и в то же время необходимо
быть спокойным, способным показать собаке своё
лидерство. Высококвалифицированный кинолог имеет
обширные знания о породе, с которой работает, об
особенностях экстерьера собаки и её характера. Специалист
должен воспитать в собаке качества, которые были
заложены в породе веками.
PPT模板下载 www.1ppt.com/moban/
节日PPT模板 www.1ppt.com/jieri/
PPT背景图片 www.1ppt.com/beijing/
优秀PPT下载 www.1ppt.com/xiazai/
Word教程 www.1ppt.com/word/
资料下载 www.1ppt.com/ziliao/
范文下载 www.1ppt.com/fanwen/
教案下载 www.1ppt.com/jiaoan/
字体下载 www.1ppt.com/ziti/
行业PPT模板 www.1ppt.com/hangye/
PPT素材下载 www.1ppt.com/sucai/
PPT图表下载 www.1ppt.com/tubiao/
PPT教程 www.1ppt.com/powerpoint/
Excel教程 www.1ppt.com/excel/
PPT课件下载 www.1ppt.com/kejian/
试卷下载 www.1ppt.com/shiti/
12.
Негативным моментом работы в этой сфере считаетсяповышенный риск профессионального травматизма.
Собаки могут быть непредсказуемыми, они способны
наносить сотруднику укусы и царапины. Правда, у
кинологов, получивших профильное образование, такие
последствия возникают очень редко. Еще не всем
следует рассчитывать на высокие заработки в сфере, как
минимум на старте карьеры. Получение прибыли
возможно при разведении собак на продажу, участии в
выставках, наличии большого опыта, который позволяет
выставлять высокие цены на услуги эксперта. Для
некоторых соискателей профессии сложность
представляет необходимость освоения больших
массивов информации.
Положительные стороны работы кинолога:
• постоянное «общение» с собаками, положительно
влияющее на психоэмоциональное состояние
человека;
• возможность помогать людям при работе в МЧС,
силовых структурах на таможне и других важных
сферах;
• шансы на получение хорошей прибыли при
ответственном отношении к своей работе и
постоянном профессиональном развитии;
• некоторые кинологи успешно совмещают работу с
собаками с другими видами деятельности.
На практике плюсы и минусы получения профессии
кинолог оказываются не так важны. На передний план
выходит отношение человека к животному. Любители
собак не замечают сложностей и отрицательных
моментов. Они получают удовольствие от самого
процесса работы с питомцами, что нередко выливается
в финансовое благополучие.
13.
Из всех животных, которыходомашнил человек, лишь одно
стало ему настоящим другом –
собака.
Собака умеет преданно любить,
хорошо приспосабливается к
различным условиям и усваивает
уроки.
В мире насчитывается около
400 пород собак
Все эти породы можно разделить на
3 группы:
03
02
01
Декоративные:
Делают жизнь
человека ярче и
интереснее.
Охотничьи:
Помогают
людям на охоте
.
Служебные:
Оказывают человеку
практическую помощь в
различных сферах
деятельности
14.
Мальтийскаякороткошерстная болонка
Померанский шпиц
Вельш-корги
Йоркширский
терьер
Котон-де-тулеар
15.
Английский сеттерВеймаранер
Ирландский сеттер
Курцхаар
Дратхаар
Венгерская выжла
16.
ДоберманРотвейлер
Немецкая овчарка
Русский черный
терьер
Кавказская овчарка
17.
Дашевская Вероника СергеевнаPPT模板下载 www.1ppt.com/moban/
节日PPT模板 www.1ppt.com/jieri/
PPT背景图片 www.1ppt.com/beijing/
优秀PPT下载 www.1ppt.com/xiazai/
Word教程 www.1ppt.com/word/
资料下载 www.1ppt.com/ziliao/
范文下载 www.1ppt.com/fanwen/
教案下载 www.1ppt.com/jiaoan/
字体下载 www.1ppt.com/ziti/
行业PPT模板 www.1ppt.com/hangye/
PPT素材下载 www.1ppt.com/sucai/
PPT图表下载 www.1ppt.com/tubiao/
PPT教程 www.1ppt.com/powerpoint/
Excel教程 www.1ppt.com/excel/
PPT课件下载 www.1ppt.com/kejian/
试卷下载 www.1ppt.com/shiti/

















 biology
biology law
law